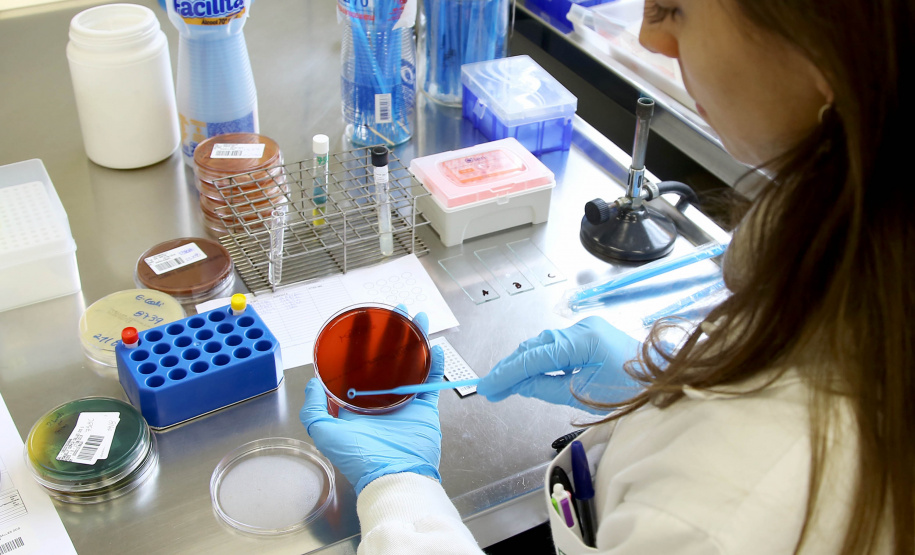
Contra o Covid-19, Governo reforça quadro de funcionários do Lacen-PR. Foto: Jaelson Lucas/AEN

O Governo do Paraná reforçou em mais de 20% o quadro de profissionais do Laboratório Central do Estado (Lacen-PR), principal responsável por exames de contraprova para a Covid-19. A equipe da Divisão dos Laboratórios de Epidemiológica e Controle de Doenças (DVLED), em São José dos Pinhais, passará de 60 para 73 agentes até o fim de abril.
O reforço no quadro de pessoal dará ainda mais agilidade ao Lacen na realização de testes do novo coronavírus. Hoje, o laboratório tem capacidade de executar até 600 exames por dia – um aumento de 400% em relação ao início da pandemia - e trabalha com a investigação de 484 casos suspeitos. Na última semana o laboratório fez cerca de duas mil análises e já descartou 2.877 casos ao longo do mês de março.
“A equipe do Lacen fez um grande esforço de trabalho nas últimas semanas e está operando à plena capacidade para dar respostas cada vez mais ágeis para a sociedade em geral e para a comunidade médica do Paraná. O laboratório tem papel fundamental na estratégia de contenção da Covid-19 e está recebendo toda a atenção do governo estadual”, afirma o secretário da Saúde, Beto Preto.
Para dar vazão à demanda gerada pela pandemia do novo coronavírus, o Governo do Estado colocou em operação a frota oficial de aeronaves, que estão se deslocando diariamente pelo Paraná para buscar exames de suspeitas da doença. “Esta medida contribuiu muito para agilizarmos a entrada e a saída dos resultados”, avalia Beto Preto.
Do total de profissionais contratados, cinco foram deslocados de outra unidade do Lacen-PR, de Curitiba, divisão especializada em vigilância sanitária e ambiental. Nove são bolsistas, de nível técnico e superior, ligados à Universidade Federal do Paraná (UFPR). O grupo começou nesta segunda-feira (30).
Outras três pessoas passarão a atuar no local ainda em abril. Serão contratações temporárias, duas delas via inexigibilidade de licitação (Lei 15.608/2007) devido à pandemia, o que viabiliza o pagamento por meio de Recibo de Pagamento Autônomo (RPA).
A outra virá de um convênio com a Organização Pan-Americana da Saúde (Opas-Brasil), instituição internacional especializada em saúde. Os acordos têm duração de três a seis meses. “O objetivo desta ação de extensão é ampliar as informações, orientação e atendimento à população diante da pandemia do coronavírus”, destacou Beto Preto, secretário de Estado da Saúde.
IMPACTO – Diretora-geral do Lacen-PR, Célia Fagundes Cruz explicou que a chegada dos novos profissionais terá um impacto geral imediato na produção do laboratório, com destaque para o recebimento e organização das amostras e a realização de laudos técnicos. Segundo ela, o laboratório consegue analisar atualmente 600 amostras por dia.
“São contratações temporárias de bioquímicos, mas que vão colaborar e muito com o Lacen-PR, já que estamos todos envolvidos com a pandemia, fazendo análises inclusive aos sábados e domingos”, disse. Além disso, destacou ela, os funcionários trabalham em escala para cobrir o expediente ampliado, entre 8 horas e 23 horas.
Diariamente, lembrou a diretora, o laboratório recebe amostras de exames de vírus variados, entre estes estão aquelas para identificar o coronavírus. Para fazer o exame as amostras passam por várias etapas desde que chegam no Lacen. A partir da entrada o resultado referente à Covid-19 sai em até 72 horas.
REFERÊNCIA – Além de ser o laboratório referenciado pelo Ministério da Saúde no Paraná, o Lacen é também o responsável por exames para exames diferenciados de brucelose, varicela e estreptococo de amostras vindas do Rio Grande do Sul, Mato Grosso e Mato Grosso do Sul.
BOLSISTAS – No total, 1.064 bolsistas atuam no Paraná no combate ao Covid-19. Eles estão sob supervisão da Secretaria de Estado da Saúde, auxiliando no atendimento em centrais de informações, atenção às divisas rodoviárias do Estado, atendimento à população em unidade de saúde, hospitais e outros estabelecimentos de saúde.
Além do Lacen, alguns foram deslocados para ajudar no Centro de Informações Estratégicas em Vigilância em Saúde (Cievs).